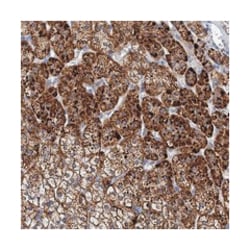
PANX2, Rabbit, Polyclonal Antibody, Abnova 100&mu;L; Unlabeled:Antibodies,

Learn More
PANX2, Rabbit, Polyclonal Antibody, Abnova™
Rabbit polyclonal antibody raised against recombinant PANX2.
Brand: Abnova PAB23512.100uL
Description
The protein encoded by this gene belongs to the innexin family. Innexin family members are the structural components of gap junctions. This protein and pannexin 1 are abundantly expressed in central nervous system (CNS) and are coexpressed in various neuronal populations. Studies in Xenopus oocytes suggest that this protein alone and in combination with pannexin 1 may form cell type-specific gap junctions with distinct properties. Multiple transcript variants encoding different isoforms have been found for this gene. [provided by RefSeq
Sequence: SNFIFDKLHKVGIKTRRQWRRSQFCDINILAMFCNENRDHIKSLNRLDFITNESDLMYDNVVRQLLAALAQSNHDATPTVRDSGVQTVDPSSpecifications
| PANX2 | |
| Polyclonal | |
| Rabbit polyclonal antibody raised against recombinant PANX2. | |
| In PBS, pH 7.5 (40% glycerol, 0.02% sodium azide) | |
| MGC119432/PX2/hPANX2 | |
| Rabbit | |
| Antigen affinity purification | |
| RUO | |
| 56666 | |
| Store at 4°C. For long term storage store at -20°C. Aliquot to avoid repeated freezing and thawing. |
|
| IgG |
| Immunohistochemistry (PFA fixed) | |
| Unconjugated | |
| Immunohistochemistry (1:50-1:200) The optimal working dilution should be determined by the end user. | |
| PANX2 | |
| PANX2 | |
| Recombinant protein corresponding to amino acids of human PANX2. | |
| 100 μL | |
| Primary | |
| Human | |
| Liquid |
Your input is important to us. Please complete this form to provide feedback related to the content on this product.
For Research Use Only